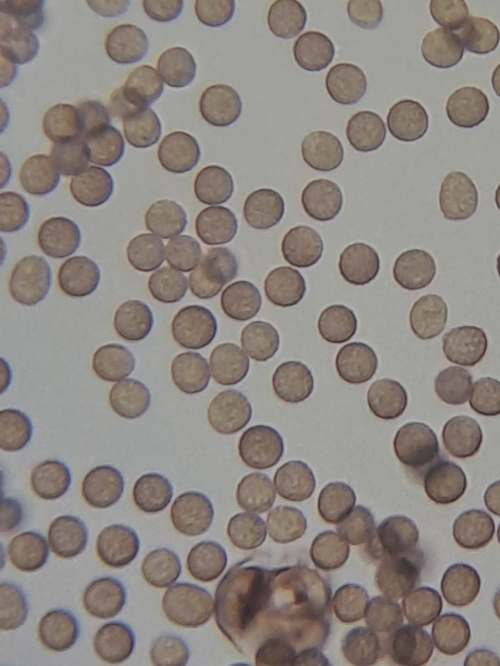

Stemonitis fusca
Stemonitis fusca is a species of slime mould. It fruits in clusters on dead wood and has distinctive tall brown sporangia supported on slender stalks with a total height of approximately 6–20 mm tall.
Slime-moulds are difficult to identify from photos; microscopic examination is usually needed. We recommend that you take a specimen and consult an expert before submitting to NatureSpot.
rotten logs
Leicestershire & Rutland Map
Enter a town or village to see local records
MAP KEY:
Yellow squares = NBN records (all known data)
Coloured circles = NatureSpot records: 2025+ | 2020-2024 | pre-2020
UK Map
Species profile
- Species group:
- Slime Moulds
- Kingdom:
- Order:
- Family:
- Records on NatureSpot:
- 2
- First record:
- 05/10/2024 (Bell, Melinda)
- Last record:
- 05/10/2024 (Bell, Melinda)
Total records by month
% of records within its species group
10km squares with records
The latest images and records displayed below include those awaiting verification checks so we cannot guarantee that every identification is correct. Once accepted, the record displays a green tick.
In the Latest Records section, click on the header to sort A-Z, and again to sort Z-A. Use the header boxes to filter the list.